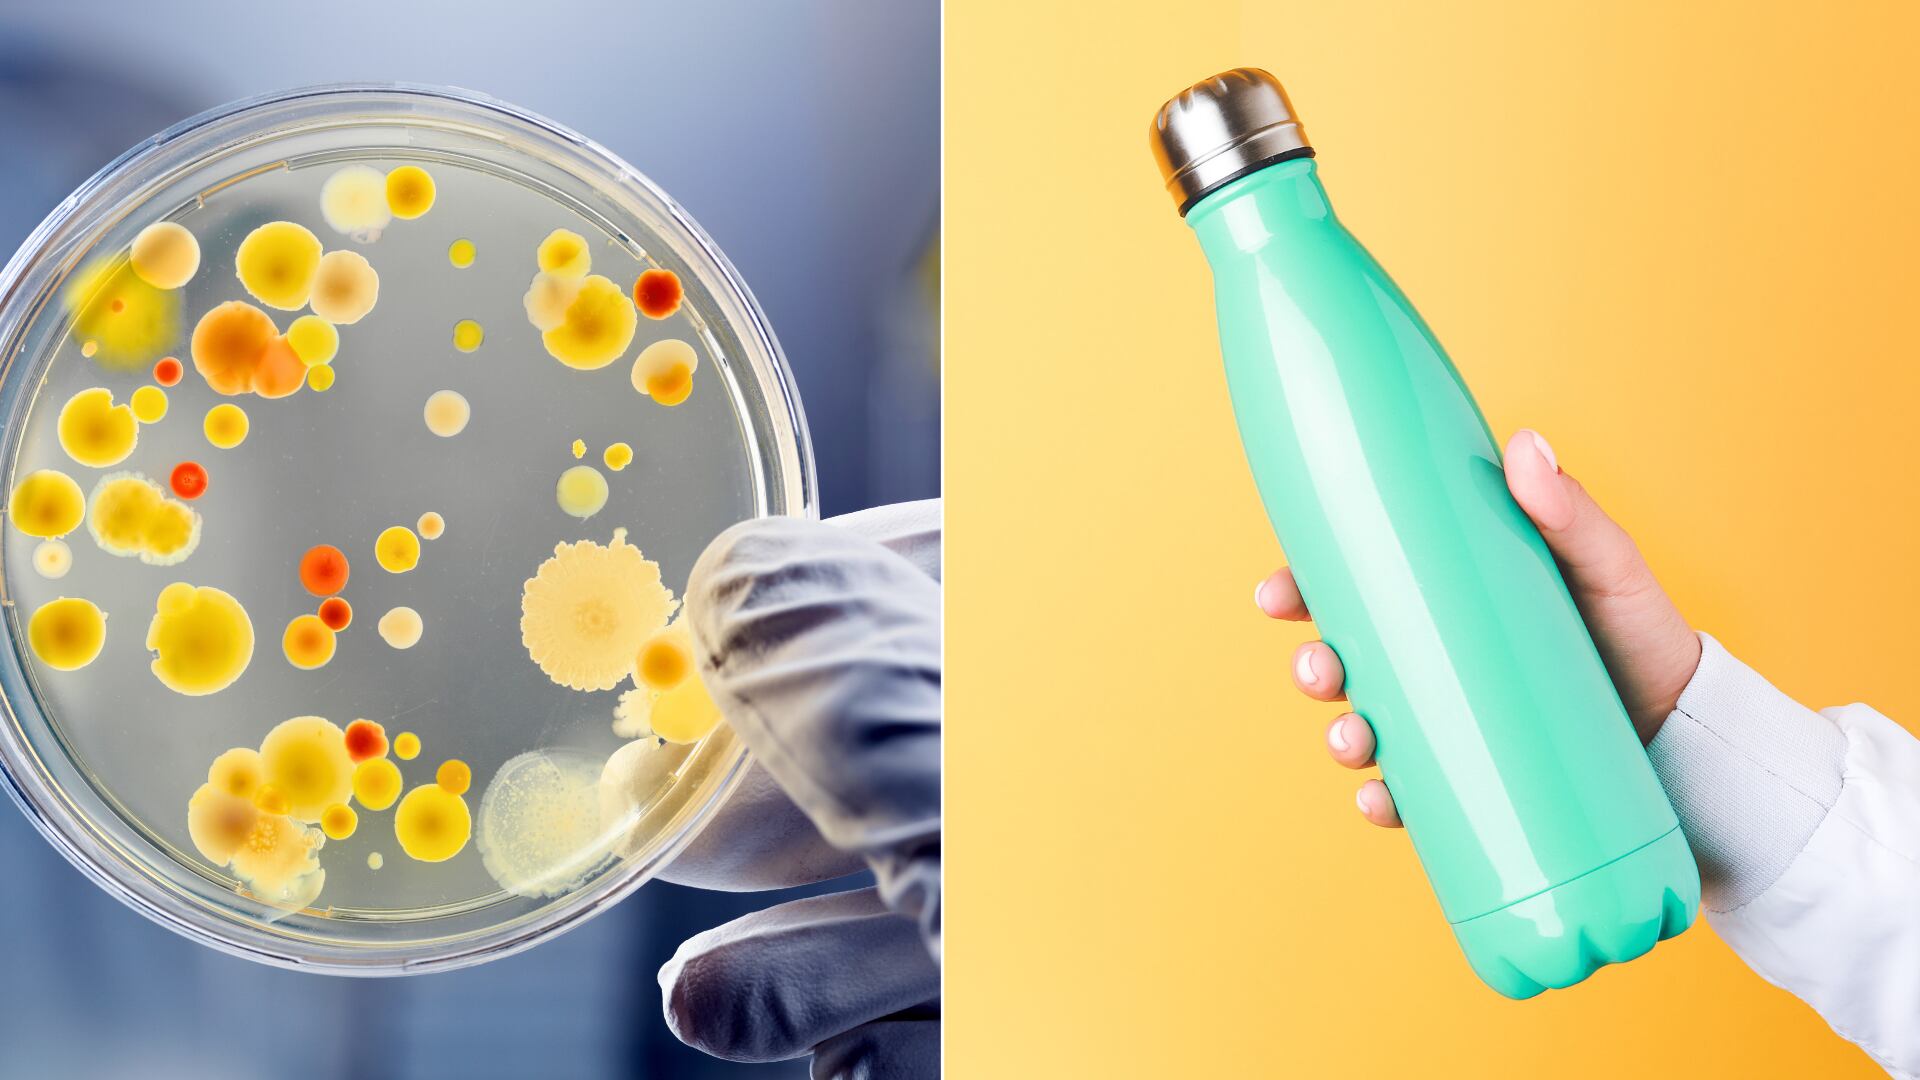
Estudios indican que botellas de agua sin lavar pueden contener millones de bacterias, superando por mucho la suciedad de un inodoro.

Un estudio reveló que un objeto común en casas y oficinas puede contener hasta 20,8 millones de bacterias, mientras un inodoro apenas alcanza 515 unidades.
Las botellas reutilizables que se utilizan a diario para hidratarse en el hogar, la oficina o centros educativos pueden representar un riesgo para la salud si no se limpian correctamente. Investigaciones demostraron que estos recipientes acumulan hasta 40.000 veces más bacterias que un inodoro.
Un análisis reveló que, en promedio, una botella de agua contiene 20,8 millones de Unidades Formadoras de Colonias (UFC), mientras que la superficie de un inodoro tiene alrededor de 515 UFC. Así lo reveló un artículo publicado por la BBC, basado en varios estudios científicos.
Aumento diario de bacterias por falta de limpieza
Investigadores de la Universidad de Henan en China señalaron que un mililitro de agua en una botella reutilizable puede contener 75.000 bacterias al inicio del día. Si no se lava adecuadamente, esa cifra puede escalar hasta los 2 millones en cuestión de horas.
Un estudio similar, desarrollado por la Universidad Purdue en Estados Unidos, analizó 90 botellas y detectó que un 15 % de los usuarios no vacía el agua del día anterior, sino que simplemente la rellena. Esta práctica facilita el crecimiento bacteriano, ya que un simple enjuague con agua no elimina los residuos acumulados.
Además, las encuestas realizadas en ambas investigaciones indicaron que solo 42 % de las personas limpia su botella cada día. Un 25 % lo hace algunas veces a la semana y un 13 % apenas un par de veces al mes. Estos datos exponen un bajo índice de higiene.
Contaminación desde la boca y las manos
Las principales bacterias encontradas en estos recipientes provienen de la boca humana, como estafilococos y estreptococos, que ingresan al contacto con la boquilla. También se detectó contaminación cruzada a través de las manos, que transmiten microorganismos tras tocar superficies como teclados, celulares o botones de ascensores.
El contacto con estas bacterias puede causar síntomas gastrointestinales como diarrea, náuseas, vómito y dolor abdominal. Los efectos dependen de la resistencia del sistema inmune de cada persona. En casos graves, ciertas bacterias podrían derivar en infecciones más serias.
Expertos aconsejan lavar las botellas diariamente con agua y jabón, y usar un cepillo especial para alcanzar el fondo, donde suele acumularse la mayor suciedad. También es importante dejar secar completamente antes de volver a usar y evitar compartirla con otras personas.
*La creación de este contenido contó con la asistencia de inteligencia artificial. La fuente de esta información es de un medio del Grupo de Diarios América (GDA) y revisada por un editor para asegurar su precisión. El contenido no se generó automáticamente.
